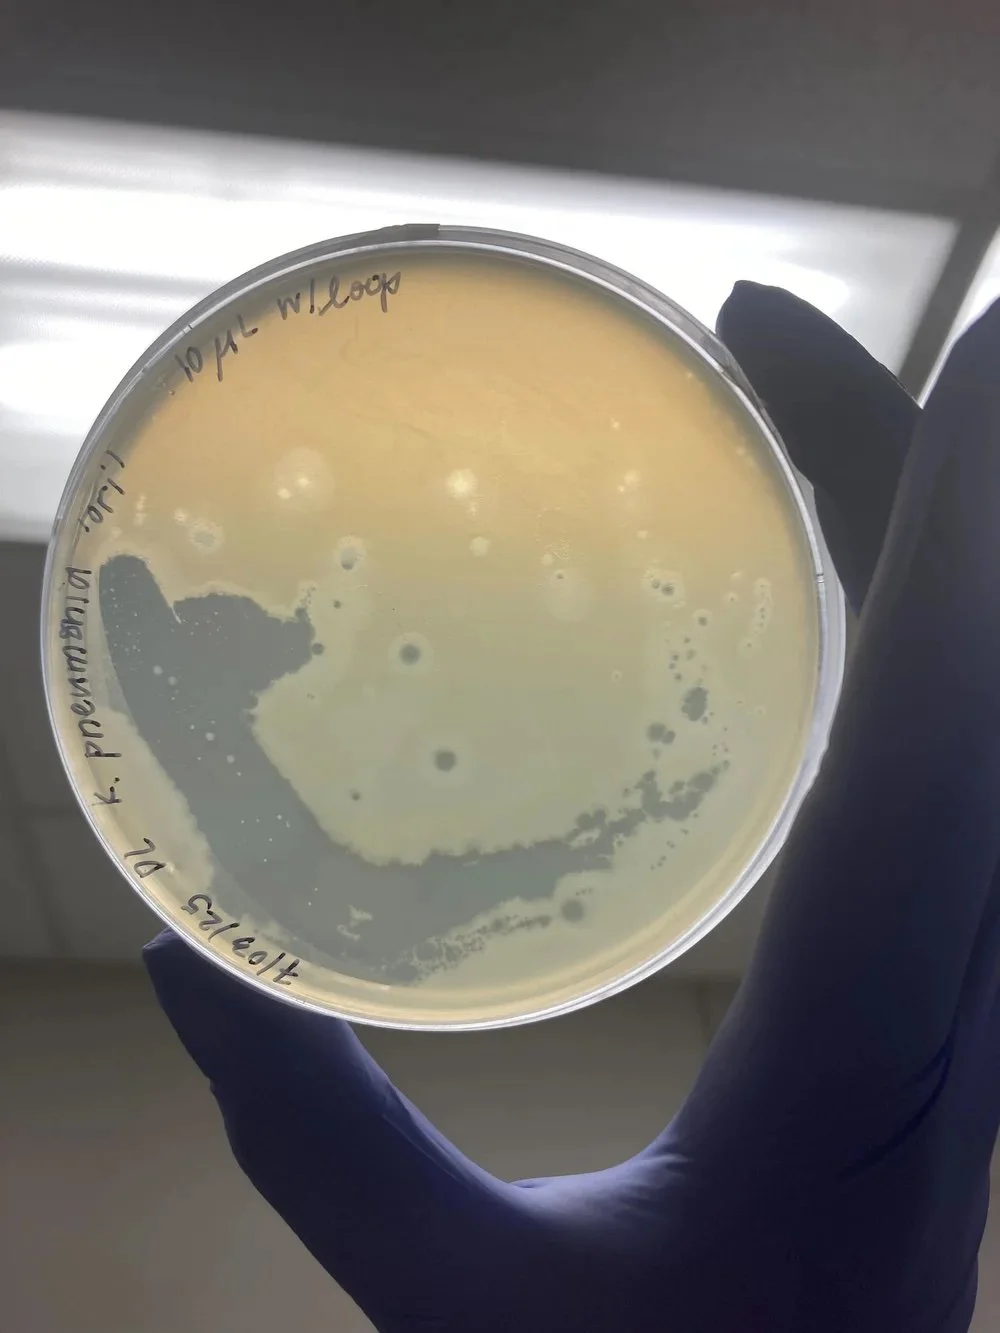
WetLab Workshop with Vivek Mutalik’s Team (<span class="sqsrte-text-color--custom" style="color: #FD0303">in-person</span>) :

Upcoming 2026 EVENTS

Phage Power Hour Speaker: Simon Roux, Ph.D.
Simon Roux is a staff scientist at the DOE Joint Genome Institute at Lawrence Berkeley National Laboratory, where he leads the Viral Genomics group studying viruses that infect microbes and their roles in natural ecosystems. His work combines multi'omics, bioinformatics, and experimental approaches to uncover viral diversity, virus–host interactions, and their impacts on microbial communities in environments such as soils and freshwater systems. Roux is also a key contributor to the development of widely used computational tools and data resources for analyzing uncultivated viruses, with a broader goal of understanding how viral activity shape ecosystem function and evolution.

Phage Power Hour Speaker: Nazzy Pakpour, Ph.D.
Nazzy Pakpour is an entomologist, children’s book author, and the co-founder and CEO of Yeast Bay Bio, a biotechnology startup developing species-specific biocontrols for pest insects using engineered yeast and RNA interference. Her work focuses on creating safer alternatives to conventional chemical insecticides for urban pest management.
Dr. Pakpour earned her BS in Entomology from UC Davis and her PhD in Microbiology, Virology, and Parasitology from the University of Pennsylvania. She later returned to UC Davis as a postdoctoral researcher studying mosquito biology and vector-borne disease. Her career spans academic research, industrial biotechnology, and science education.

Phage Power Hour Speaker: Galo Garcia, Ph.D.
How to See the Invisible: Adventures in Cells, Microscopes, and Micro Worlds
Abstract:
We’ll explore how scientists study life that’s too small to see — from single cells that can “hibernate” when their pond dries up, to tiny antenna-like structures inside our own cells that help guide brain development. Galo Garcia will share stories from his research using advanced microscopes and even 3D-printed micro-habitats to watch living cells in action. We’ll discuss what his work looks like today as a scientific consultant, helping labs and biotech companies solve complex biological questions. Alongside this, Galo mentors high school students as they learn to think and work like scientists. All are welcome. No prior knowledge needed — just curiosity.
BIO:
Dr. Galo Garcia is a molecular and cell biologist who studies how living cells organize and adapt at microscopic scales. He earned his Ph.D. from UC Berkeley and has worked at the intersection of biology, imaging, and data analysis— from studying rare genetic disorders to creating custom tools for observing single-celled organisms. He now runs SciBud Consulting, where he helps research teams design experiments and interpret data. Galo loves sharing science with students and encouraging curiosity-driven exploration.

Phage Power Hour Speaker: Denise N. Bronner, Ph.D.
Denise N. Bronner, Ph.D. is a microbiologist and immunologist whose scientific roots span the University of Michigan, where she earned her doctorate, and UC Davis, where her postdoctoral research investigated how commensal Enterobacteriaceae shape susceptibility to Salmonella infection work published in Nature Microbiology and Cell Host & Microbe. Her foundational training in host-pathogen interactions and microbial ecology gives her a distinct lens on the broader life sciences ecosystem.
After completing her postdoc, Denise made a deliberate pivot from the bench to industry and strategy. She joined Johnson & Johnson as a Director, leading global commercial efforts and cross-functional teams including work supporting the VISIBLE trial, published in JAMA Dermatology. She later founded Empactful Ventures, a boutique advisory firm at the intersection of pharma commercial strategy, clinical trial innovation, and patient advocacy, where she secured $20M+ in capital and contracts.
She has delivered 70+ speaking engagements across industry, academia, and advocacy, and mentors emerging scientists through Charles R. Drew University's BIP Accelerator and TechStars. Denise believes her most powerful credential is knowing what it means to be a scientist first and she brings that perspective to every room she enters, especially those filled with scientists figuring out what's next.

Phage Power Hour Speaker: Gary Trubl, Ph.D.
Gary Trubl is a microbiologist and research scientist at Lawrence Livermore National Laboratory whose work focuses on understanding viruses and their interactions with microbial communities in environmental systems, particularly soils. His research integrates meta-omic approaches and techniques such as stable isotope probing to characterize virus–microbe dynamics and their broader impacts on ecosystem processes and biogeochemical cycles. With academic training spanning a Ph.D. from Ohio State University and earlier degrees in environmental sciences, Trubl’s interdisciplinary interests include microbial ecology, virology, astrobiology, and biotechnology. He is also committed to education and outreach, emphasizing the role of scientists in mentoring and shaping future generations while advancing knowledge of how viruses influence microbial physiology and ecosystem function.

Phage Power Hour Speaker: Mark Mimee, Ph.D.
Mark Mimee is an Assistant Professor of Microbiology and Molecular Engineering at the University of Chicago, where he leads a research program focused on engineering the microbiome using synthetic biology approaches. His work centers on genetically modifying commensal bacteria and bacteriophages to create “living devices” that function as biosensors and cell-based therapeutics for infectious, inflammatory, and antibiotic-resistant diseases. By developing tools to precisely control the activity and composition of microbial communities, Mimee aims to better understand microbiome function while advancing new strategies for improving human health. His interdisciplinary research bridges microbiology, bioengineering, and host–pathogen interactions, with a long-term vision of harnessing the microbiota for both fundamental discovery and translational medical applications.

Phage Power Hour Speaker: Shannon Bennett, Ph.D.
Shannon Bennett is a virologist and science leader who serves as Chief Science Officer and Dean of Science and Research Collections at the California Academy of Sciences, where she oversees the institution’s global scientific research, exploration efforts, and vast collection of nearly 46 million specimens. Her research focuses on understanding infectious diseases—particularly mosquito-borne viruses like dengue—and their connections to environmental change, while also advocating for the importance of sustained scientific research in addressing global challenges such as biodiversity loss, climate change, and public health.

2-Day WetLab Workshop with Joanne Emerson’s Team (in-person @ UC Davis) : (Tentatively Scheduled mid-September)
Location: In person, Davis, CA
Date: Tentatively, mid-September (Dates will be finalized by mid-June 2026)
Format: 2-day workshop
Participants will stay in Davis, CA (housing will be covered by the Phage Pathways Program).
Workshop focus: Sample collection and processing, along with a viral DNA extraction protocol optimized by Joanne Emerson’s lab.
Emerson Lab Interests:
Led by Dr. Joanne Emerson, the lab studies how viruses shape microbial communities in soils and plant-associated environments. Using metagenomics and bioinformatics, the team uncovers viral diversity and investigates how viruses influence ecosystem processes such as carbon and nutrient cycling, particularly under environmental changes like drought or agricultural management. Their work highlights viruses as dynamic regulators of microbial communities and explores their potential applications in improving soil health and sustainable agriculture.

Phage Power Hour Speaker: Jeremy Barr Ph.D.
Jeremy Barr completed his PhD in microbiology at The University of Queensland in 2011. He then moved to San Diego, USA to complete a postdoctoral position under the tutelage of Prof. Forest Rohwer at San Diego State University. While there he studied the interactions of bacteriophage with mucosal surfaces and was involved in a world-first phage therapy case treating a patient with disseminated, multidrug-resistant infection. In 2016, he joined Monash University's School of Biological Sciences where he is currently an Associate Professor and Group Leader. His research group studies bacteriophages and their interactions with their bacterial hosts and the human body. In 2020, he joined the Centre to Impact AMR where he leads the Monash Phage Foundry as an in-house manufacturing facility. In 2024, he was awarded a prestigious NHMRC Investigator Fellow L1 in recognition of their translational work using phage therapy to combat antimicrobial resistance. In 2025, he was promoted to full Professor at Monash University in the School of Biological Sciences.

Phage Power Hour Speaker: Jessica Enogieru PharmD, Ph.D.
Dr. Jessica Enogieru is a Sr. Scientist in the Pharmacokinetics and Drug Metabolism (PKDM) department at Amgen in South San Francisco. Her work focuses on absorption, distribution, metabolism, excretion and transport (ADMET) evaluation of small molecules including protein degraders. She earned her PharmD from the University of Florida, completed a PGY1 residency with Florida A&M University, and received her PhD from the University of California San Francisco, where she studied functional genomics and pharmacogenomics of SLC transporters. Dr. Enogieru has authored original research articles & review papers focused on the impact of transporters on small molecule disposition.

Phage Power Hour Speaker: Wallace Marshall, Ph.D.
Wallace Marshall is a professor of biochemistry and biophysics at the University of California, San Francisco whose research explores the fundamental design principles that govern how cells build, organize, and regenerate their structures. With a background spanning electrical engineering and biochemistry, his work integrates physical, mathematical, and engineering approaches to understand how cellular systems encode shape, control organelle size, and carry out complex behaviors, often using single-celled organisms as model systems. His lab employs a combination of genomics, imaging, and computational modeling to investigate processes such as pattern formation, cellular architecture, and regeneration, contributing to a broader understanding of how biological systems function as dynamic, information-processing entities.

Phage Power Hour Speaker: Marie Gourdet, BSN, MSN, Ph.D.(candidate)
Marie Gourdet is a registered nurse, health policy scholar, and current PhD candidate in the Nursing Health Policy program at the University of California, San Francisco, where she also earned her master’s degree in the same field. Drawing on more than a decade of experience as an emergency room nurse in both North Carolina and California, her work is grounded in frontline clinical care and a commitment to addressing structural health inequities. Her research focuses on the intersection of HIV and people who use drugs, examining how overlapping social, structural, and behavioral factors shape access to prevention and treatment—an urgent public health challenge, as HIV continues to disproportionately impact marginalized populations including people who inject drugs. Building on this focus, her recent publication contributes to the growing body of research aimed at health outcomes for underserved communities, particularly by highlighting gaps in current approaches and the need for more equitable, person-centered interventions.

Phage Power Hour Speaker: Pragyesh Dhungel, Ph.D.
Pragyesh Dhungel is a biotechnology entrepreneur and molecular virologist with over 14 years of experience in research and drug development, ranging from early discovery to clinical-scale drug product manufacturing. As the Co-Founder and executive leader of Mivax Therapeutics, he applies a first-principles approach to overcoming the delivery and scalability hurdles of solid tumor immunotherapies. His technical expertise, honed through research at Sandia National Laboratories and The Scripps Research Institute, is matched by a deep-seated commitment to education and mentorship. With five years of teaching university-level Microbiology at Kansas State University and a track record of mentoring junior scientists and interns, Pragyesh specializes in breaking down complex concepts and guiding teams through experimental unknowns. By merging the rigor of a seasoned researcher with the communication skills of a dedicated educator, he translates advanced scientific discoveries into high-performing teams and real-world therapeutic solutions.

JGI Bioinformatics workshop Day 1 (virtual) : Tentative Schedule
Introduction to JGI/Bioinformatics Workshop
(Simon Roux, Natalia Ivanova, and Rekha Seshadri)
JGI: The DOE Joint Genome Institute (JGI), based at Lawrence Berkeley National Laboratory, is an AI-driven genomic science facility supporting DOE missions in energy and biotechnology. It generates and analyzes large-scale genomic and metagenomic data from plants, fungi, and microbial systems, providing researchers with open-access tools and datasets to study complex biological processes and advance environmental and biotechnological applications

JGI Bioinformatics workshop Day 2 & 3 (in-person) : Tentative Schedule
In-person: Berkeley, CA
JGI/Bioinformatics: Microbial Genomics and Metagenomics Workshop:
Hands-on training program designed to teach researchers how to analyze and interpret viral genomic and metagenomic data using the Integrated Microbial Genomes & Microbiomes (IMG/M) system. Participants engage in practical exercises involving comparative analysis, visualization, and interpretation of sequencing datasets. The workshop also provides foundational overviews of sequencing technologies, genome assembly, annotation, and metadata curation

Phage Power Hour Speaker: Mikayla Borton, Ph.D.
Dr. Mikayla Borton is an Assistant Professor in the Department of Food Science and Human Nutrition and co-leads the Microbial Ecosystems Lab at Colorado State University. Dr. Borton’s research focuses on understanding microbiomes through multi-omics and systems biology approaches, with applications spanning host, environmental, and climate-related challenges. Her work brings together microbial ecology, genomics, and data science to better understand how microbial communities shape the world around us. She will discuss her work on the Genome Resolved Open Watersheds (Rivers) project and multi-omics approaches for understanding climate change impacts in wetlands.

Phage Power Hour Speaker: Alissa Bleem, Ph.D.
Alissa Bleem is a researcher in biological sciences at the National Laboratory of the Rockies (formerly National Renewable Energy Laboratory), where her work focuses on advancing synthetic biology and microbial engineering for the bioeconomy. Her research centers on functional genomics, high-throughput screening, and protein engineering for conversion of waste and renewable feedstocks to energy, chemicals, and materials. Through interdisciplinary approaches that combine experimental and computational platforms, Bleem seeks to optimize microbial systems for process integration and demonstration at scale.

Phage Power Hour Speaker: Nani Sinacola
Nani Sinacola works in personal branding, storytelling, and workforce development, helping students and professionals across all career stages navigate biotech, tech, and innovation with stronger communication, networking, and interview strategy. Through her work with the Harvard Ed Portal and workshops on authenticity and personal branding in biotech at LabCentral, she helps people translate technical skills, experience, and nontraditional paths into clear, compelling narratives. She is also the founder of We STEAM Rockets, a community-driven initiative supporting the next generation of STEAM talent through career development and industry exposure.

Phage Power Hour Speaker: Becky Mitschele, M.S.
Becky Mitschele is an National Pollutant Discharge Elimination System (NPDES) permit writer who works at the intersection of environmental regulation and microbiology, focusing on wastewater systems and their impact on public and ecosystem health. Her work involves analyzing influent and effluent wastewater samples, managing biosolids, and working with large scale animal agriculture facilities to better understand treatment processes, manure management, and discharge outcomes under the NPDES permitting program. She provides insight into navigating careers in environmental science, policy making, and public service, while also offering an overview of wastewater permitting, regulatory considerations, and current “hot topics” in wastewater management.
Prior to joining EPA in 2009, Becky had a variety of jobs, including working as a soil science lab technician, an emergency preparedness planner, remediating leaking underground storage tanks sites, and managing nonpoint source pollution activities for the Chemehuevi Indian Tribe. She holds a Bachelor of Science degree in Geography and Environmental Studies from the University of Newcastle, Australia and a Master of Science degree in Natural Resources and Environmental Management from the University of Hawai'i.

Phage Power Hour Speaker: Graham Hatfull, Ph.D. (in-person)
Graham Hatfull is the Eberly Family Professor of Biotechnology and an HHMI Professor at the University of Pittsburgh, where he serves as the lead scientist for the SEA-PHAGES program, guiding its overall scientific vision and research goals. Trained in the United Kingdom, he earned his Ph.D. at the University of Edinburgh and completed postdoctoral research at Yale University and the Medical Research Council in Cambridge, UK with renowned scientists including Fred Sanger. His research focuses on understanding the biology and genetics of Mycobacterium tuberculosis, the bacterium responsible for tuberculosis, by leveraging Mycobacteriophages—viruses that infect mycobacterial hosts—as powerful experimental tools. Using the fast-growing model organism Mycobacterium smegmatis, his work explores how phages can be used to investigate mycobacterial gene function and develop innovative molecular tools, advancing efforts to better understand and ultimately combat one of the world’s most persistent infectious diseases.
IN-PERSON at San Francisco State University, CA,
Burk Hall 210
WetLab Workshop with Vivek Mutalik’s Team (in-person) :
Workshop: The Mutalik lab from Lawrence Berkeley National Lab will conduct a 5 (full-)day workshop at San Francisco State University. The workshop will provide scholars training in bacterial culturing, Phage Isolation, and Phage genome extraction.
Location: 1600 Holloway Avenue, San Francisco, CA 94132 (Hensil Hall 116)
Mutalik Lab Interests: Led by Dr. Vivek Mutalik, the Mutalik Lab at Lawrence Berkeley National Laboratory focuses on advancing microbial and bacteriophage biology using high-throughput approaches to functionally characterize genes from microbes and phages, including those in metagenomic samples. The lab investigates the mechanisms of phage–host interactions and their roles in antibiotic resistance and host fitness, while also engineering phages and microbial communities for applications in biotechnology and medicine, including the design of phage–antibiotic therapies and synthetic genetic tools.

Phage Power Hour Speaker: Stephanie Johnson, Ph.D.
Dr. Stephanie Johnson is a scientist-engineer working to bring advances in machine learning and computational imaging to address unmet patient needs with novel therapeutics. After her PhD and postdoctoral training in biochemistry and molecular biophysics, she moved into software engineering, and into drug discovery. She currently leads a team of software engineers at a Bay Area biopharmaceutical company, interfacing closely with scientists to advance early drug discovery programs. She is passionate about the potential for machine learning and imaging to unlock new avenues for treating disease, and about mentoring the next generation of scientists and software engineers to push these advances even further.

Phage Power Hour Speaker: Rachel Hatano, Ph.D.
Dr. Rachel Hatano is a PhD-trained scientist and biotech leader working at the intersection of research, innovation, and startup ecosystem development. She is currently part of the MBC BioLabs, where she supports early-stage life science companies by helping build collaborative environments that accelerate scientific discovery and company growth. Her background includes training in biological engineering, with research focused on cardiovascular tissue engineering and stem cell–based systems.
In addition to her scientific expertise, Dr. Hatano has experience in translational research and industry, including work in assay development and biotech entrepreneurship. She is passionate about fostering inclusive, community-driven innovation in biotech and connecting scientists, founders, and investors to advance new therapeutic approaches.

Phage Power Hour Speaker: Aneesa Valentine, M.S.
Aneesa Valentine is a computational scientist and engineer with PhD training in computational genomics and extensive professional experience across data science, data engineering and applied machine learning in the life sciences. She has worked across industry and research to build scalable data infrastructure and analytics pipelines for genomics in biotech and is the founder of ImpaktBio: an educational services company focused on hands-on training in bioinformatics, data science and AI for the life sciences. Aneesa has partnered with several non-profits and enterprise biopharma organizations across the US, developing and implementing bioinformatics curriculum for effective user enablement. Additionally, she recently co-founded The Black Life Sciences Collective to expand access to technical training and community in computational biology. She is deeply committed to democratizing computational genomics, data science and engineering by making these skills accessible, practical and career-relevant for scientists and learners from diverse backgrounds.

Phage Power Hour Speaker: Catherine Mageeney, Ph.D.
Catherine Mageeney is a principal member of the technical staff in bioengineering and biotechnology at Sandia National Laboratories, where she applies her expertise in phage biology and genetics to a wide range of challenges in bioscience. Her work centers on bacteriophages, viruses that infect bacteria, which are the most abundant and diverse biological entities on Earth, with an estimated 10³¹ yet to be fully explored. Mageeney’s research leverages this immense diversity as a versatile toolkit for solving complex biological problems, from combating infectious diseases to advancing applications in biomanufacturing, and biotechnology. With a strong background in molecular biology and microbial systems, she integrates genomic analysis, phage discovery, and functional characterization to better understand and harness phage-host interactions. Since her early introduction to phage research as an undergraduate at Cabrini College, she has built a career in discovery-driven science and now leads and mentors researchers, fostering the next generation of scientists while advancing innovative, phage-based solutions.

Phage Power Hour Speaker: Lyndsay Rankin, Ph.D.
Coastal wetlands provide critical ecosystem services, including flood protection, habitat for diverse species, and long-term carbon storage, often exceeding that of terrestrial forests, making them essential for climate change mitigation. Lyndsay Rankin is a coastal scientist whose work in the San Francisco Bay–Delta focuses on understanding and quantifying these benefits to inform effective management and restoration. Her research integrates long-term datasets, including regional marsh vegetation surveys, with field-based measurements of soil carbon and greenhouse gas fluxes across natural and restored wetlands. By collecting and analyzing soil cores, she evaluates how organic carbon accumulates over time, while also examining how vegetation communities, microbial processes, salinity gradients, and tidal inundation influence carbon storage and emissions. Using greenhouse gas chamber analyzers, she measures carbon dioxide and methane fluxes to better understand the dynamic balance between carbon sequestration and release. Through this work, she aims to identify the key drivers of carbon cycling in coastal wetlands, providing science-based insights to support restoration strategies and enhance the resilience and climate benefits of Bay Area ecosystems.

Phage Power Hour Speaker: Danny De Sloover
With a uniquely cross-disciplinary career spanning agricultural biotech and clinical genomics, Danny De Sloover has built and scaled innovative sequencing and genetic analysis systems across both industries. From early work at Dow (now Corteva) advancing genome editing (ZFNs) and next-generation sequencing (Solexa -> Illumina, 454, PacBio) for crop improvement, to developing ultra-deep tumor profiling assays in the clinical space, their experience bridges cutting-edge science with real-world application.
As a founding lab member at Color, Danny helped create a clinical sequencing operation that delivered over one million results, emphasizing human-centered design and clear communication of complex data. Most recently, Danny led large-scale metagenomic efforts in agriculture at Pattern Ag, translating sophisticated biological insights from shotgun metagenome sequencing into actionable outcomes for row-crop farmers

Phage Power Hour Speaker: Faith Dukes, Ph.D.
Faith Dukes, Ph.D., serves as the Director of K–12, University, and Faculty STEM Education Programs at Lawrence Berkeley National Laboratory, where she leads initiatives that connect cutting-edge scientific research with education and workforce development. With over 20 years of experience spanning research, informal science education, and federal policy, her work focuses on building pathways for the next generation of scientists and strengthening connections between research institutions and educators at all levels. Prior to Berkeley Lab, she developed innovative public-facing science programs at the MIT Museum and served as an AAAS Science and Technology Policy Fellow at the National Science Foundation, where she contributed to national STEM education and workforce efforts. Trained as a physical chemist, she earned her Ph.D. from Tufts University studying photocatalytic semiconductors and holds a Bachelor of Science from Spelman College. Her career reflects a consistent commitment to bridging research, education, and policy in service of a stronger scientific workforce.

Phage Power Hour Speaker: Oscar Luo, MBA, CLS, MLS(ASCP)CM, SBBCM
Oscar Luo, MBA, CLS, MLS(ASCP)CM, SBBCM, is a laboratory professional specializing in immunohematology, currently serving as Manager of the Immunohematology Reference Laboratory for the American Red Cross in the Northern California Coastal Region. He earned a Bachelor of Science in Biological Sciences from the University of California, Davis, and a Bachelor of Science in Medical Laboratory Science from the University of Washington, where he also completed his Clinical Laboratory Scientist training. Prior to joining the Red Cross, he spent approximately four years at the University of Washington Medical Center’s Transfusion Services Laboratory, building extensive experience in complex blood banking and transfusion support, which now informs his leadership in advancing safe and effective blood services.
https://sfsu.zoom.us/j/82133983760?pwd=4VWnOchrZWnYRWZFVWJ6TlTegFcFKb.1
